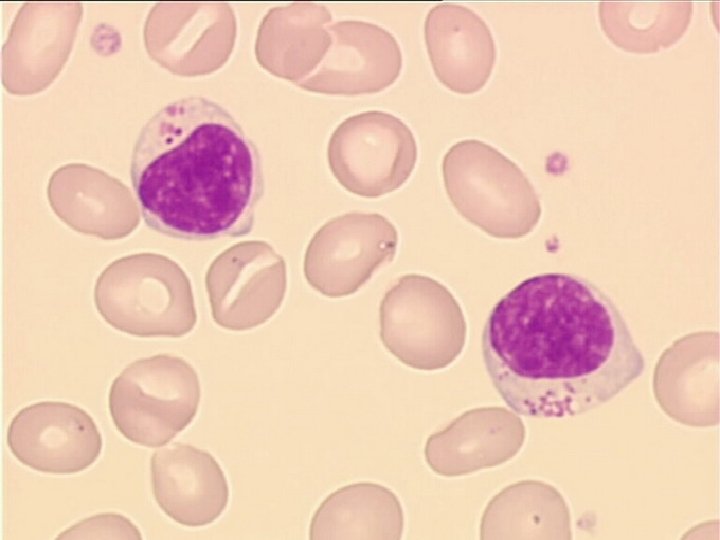

LIGNEE LYMPHOCYTAIRE IINTRODUCTION LES LYMPHOCYTES Support cellulaire de

- Slides: 41
LIGNEE LYMPHOCYTAIRE
I-INTRODUCTION LES LYMPHOCYTES: § Support cellulaire de la défense immunitaire spécifique § 25 – 40 % des globules blancs dans le sang périphérique § Moins de 20 % dans le myélogramme.
I-INTRODUCTION 3 populations de lymphocytes: * Lymphocytes T: Ø Différentiation dans le thymus: lymphocytes thymo-dépendants Ø Impliqués dans l’immunité à, médiation cellulaire
I-INTRODUCTION * Lymphocytes B: Ø Différentiation dans la moelle osseuse Ø Immunité à médiation humorale
I-INTRODUCTION * Lymphocytes nuls, non T, non B: v Lymphocytes naturel Killer: cellule NK: Tuent naturellement les tumeurs v Lymphocytes Killer: cellules effectrices de la cytotoxicité dépendante des Ac: ADCC v LAK: lymphokine actived Killer
II- ORIGINE ET CIRCULATION DES CELLULES LYMPHOÏDES 1. Origine et migration initiale des précurseurs § La lymphopoïèse commence au niveau du foie fœtale à partir de la 6 ème semaine. § La MO se substitue à partir du 4 ème mois. ØDevient prépondérante à partir du 6ème mois ØExclusive à la naissance
II- ORIGINE ET CIRCULATION DES CELLULES LYMPHOÏDES § Les cellules souches lymphoïdes proviennent de la cellule souche pluripotente médullaire. § Cellule souche pluripotente Cellules souches lymphoïdes précurseurs des lymphocytes T et des lymphocytes B § Pré B Différentiation LB mature ( moelle) § Pré T différentiation LT mature ( Thymus ) ( 1ère étape de différentiation) et acquisition de la spécificité immunitaire)
II- ORIGINE ET CIRCULATION DES CELLULES LYMPHOÏDES q Les lymphocytes B ( LB) matures et (LT) ou thymocytes matures zones T dépendantes des organes lymphoïdes périphériques: - ganglion - la rate et - les différents formations lymphoïdes muqueuses digestives( plaque de Payer) et respiratoires ou ils achèvent leur maturation : fonctionnellement mature suite à un contact avec un Ag:
II- ORIGINE ET CIRCULATION DES CELLULES LYMPHOÏDES les LB et LT gagnent la circulation lymphatique , puis sanguine. On estime qu’il ya : 70 à 80 % 5 à 10 % LT LB circulants
II- ORIGINE ET CIRCULATION DES CELLULES LYMPHOÏDES 2. Recirculation des lymphocytes matures: § Les LB et LT nés dans les organes lymphoïdes à la suite d’une stimulation antigénique: Canal thoracique dans la circulation générale § Permet: atteindre les organes lymphoïdes périphériques très éloignés de leur lieu de naissance; § Peuvent: rencontrer à nouveau un Ag d’un clone identique activation et apparition § Recirculation permanente : dispersion dans tout l’organisme des lymphocytes éduqués, aptes à reconnaitre les différents Ag
III- LYMPHOPOÏÈSE 1. Lymphopoïèse T: Cellule souche pluripotente cellule souche lymphoïde pré T Thymus. Pré T maturation Lymphocytes (1 erstade de différentiation) vont apparaitre des marqueurs de différentiation permettant aux lymphocytes de : - Reconnaitre l’Ag - Distinguer le soi du non soi: tolérance du soi
III- LYMPHOPOÏÈSE 1. Lymphopoïèse T: (suite) § Les marqueurs de la membrane des lymphocytes T sont des molécules antigéniques de surface reconnus par des anticorps monoclonaux. § Ce sont des marqueurs de différentiation ou cluster de différentiation: CD § A côté des CD, les LT portent un récepteur pour l’Ag: c’est : TCR
III- LYMPHOPOÏÈSE 1. Lymphopoïèse T: (suite) Dans la zone corticale: Les LT acquièrent un certain nombre de marqueurs: - CD 7 CD 1 CD 2 Apparition simultanée de CD 4 et CD 8
III- LYMPHOPOÏÈSE 1. Lymphopoïèse T: (suite) Dans la zone médullaire: apparaissent d’autres marqueurs • • TCR Disparition du CD 1 avec apparition du CD 4 ou CD 8 Apparition du CD 3: fin de maturation thymique Ensuite: § Récepteur pour le Fc des Ig § Apparition des marqueurs du système HLA classe I
III- LYMPHOPOÏÈSE 1. Lymphopoïèse T: (suite) Les lymphocytes thymus sont: LT matures mais fonctionnellement immatures migration : zones T dépendantes des organes lymphoïdes périphériques contact avec l’Ag: fonctionnellement mature
III- LYMPHOPOÏÈSE 1. Lymphopoïèse T: (suite) A) Activation antigénique: apparition des marqueurs d’activation: CD 25: récepteur de l’IL 2 HLA classe II B) Stimulation antigénique: Apparition de populations lymphocytaires de fonctions différentes.
III- LYMPHOPOÏÈSE 1. Lymphopoïèse T: (suite) B) Stimulation antigénique: Apparition de populations lymphocytaires de fonctions différentes. q LT CD 4 hélper + LT suppresseur: régulation de la réponse immune q LT CD 8 cytotoxique: cytotoxicité restreinte et spécifique d’Ag: effecteurs de l’immunité à médiation cellulaire q LT CD 4 mémoire: sécréteurs de lymphokines: effecteurs de l’HSR
III- LYMPHOPOÏÈSE 2. Lymphopoïèse B: A) Différentiation au niveau de la MO/ indépendante de toute stimulation antigénique: Pré B MO LB mature exprime l’Ig de surface: (Ig M et Ig D) Au cours de cette différentiation: apparition des marqueurs de différentiation
III- LYMPHOPOÏÈSE 2. Lymphopoïèse B: A) Différentiation au niveau de la MO/ indépendante de toute stimulation antigénique: (suite) Cellule souche précurseurs des LB Pro B: üHLA DR classe II üCD 19 üCD 20 üCD 10: Ag calla
III- LYMPHOPOÏÈSE 2. Lymphopoïèse B: A) Différentiation au niveau de la MO/ indépendante de toute stimulation antigénique: (suite) Pré B: ü HLA DR classe II ü CD 19 ü CD 20 LB mature: ü HLA DR classe II ü CD 19 ü CD 20 ü CD 21 et CD 22, Ig de surface: reconnaissance des Ag
III- LYMPHOPOÏÈSE Ensuite les LB migrent voie sanguine Zones T dépendantes des organes lymphoïdes périphériques contact avec l’Ag.
III- LYMPHOPOÏÈSE 2. Lymphopoïèse B: B) Activation dépendante de l’Ag au niveau des organes lymphoïdes périphériques. Suivant la nature de l’Ag, les LB peuvent être activés directement par l’Ag ou par L’intermédiaire des IL sécretés par les LT CD 4 helper. § § Pour les Ag proteiques: intervention des LT CD 4 helper Pour les Ag de nature glucido-lipidiques: activation directe des LB
III- LYMPHOPOÏÈSE 2. Lymphopoïèse B: B) Activation dépendante de l’Ag au niveau des organes lymphoïdes périphériques ( suite) Les marqueurs des LB activés: *HLA DR * CD 19, CD 20 * CD 23 * Ig de surface Les LB activés vont se transformer en plasmocytes sécréteurs d’anticorps spécifiques: 1 seul type d’Ig: (M, A, G, E, D): Immnité à médiation humorale
III- LYMPHOPOÏÈSE 2. Lymphopoïèse B: C) Les autres cellules lymphoïdes « non T » « non B » Cytotoxicité non restreinte et non spécifique Ø cellules K: cellule à cytotoxicité non restreinte, médié par les Ac Ø cellule NK: cellule natural Killer: LGL (Large Granular Lymphocyte): CD 16
IV-ASPECTS MORPHOLOGIQUES Lignée lymphocytaire - faiblement représentée dans le sang - Origine: • Moelle osseuse • Réaction lymphocytaire - Il en existe deux types: Les petits lymphocytes Les grands lymphocytes
IV-ASPECTS MORPHOLOGIQUES Petite cellule au noyau mature, et couronne de cytoplasme peu abondante Petit Lymphocyte Grande cellule, au cytoplasme hyperbasophile Grand lymphocyte
IV-ASPECTS MORPHOLOGIQUES • Population lymphocytaire : 8 à 12 % de lymphocytes B, 70 à 80 % de lymphocytes T et 5 à 15 % de cellules NK.
IV-ASPECTS MORPHOLOGIQUES Petit lymphocyte • cellule arrondie, de 8 à 12 μm de diamètre. • Rapport N/C élevé • Noyau très dense, rouge-violet foncé, arrondi avec parfois une petite encoche ou dépression. • C'est au niveau de cette dépression que l'on observe un petit cytoplasme bleuté.
IV-ASPECTS MORPHOLOGIQUES La taille est à peine supérieure à celle d'une hématie. Le cytoplasme est parfois modérément basophile Petit lymphocyte
IV-ASPECTS MORPHOLOGIQUES Grand lymphocyte le diamètre varie de 12 à 15 μm, un rapport N/C moins élevé. Noyau ovalaire ou quadrangulaire Chromatine dense, d'aspect plus ou moins laqué avec des craquelures ou marbrures. • Cytoplasme translucide, parfois discrètement bleuté • Peut contenir quelques granulations rouges (de 5 à 30), définissant les grands lymphocytes • •
IV-ASPECTS MORPHOLOGIQUES Cellule avec un noyau à chromatine dense Un rapport N/C élevé. Parfois on observe un discret nucléole, comme sur cette image. Grand lymphocyte
V- FONCTIONS 1. réponse immunitaire par l’immunité - cellulaire: LT - Humorale: LB/ activation de plusieurs clones sécréteurs d’Ac 2. Activation des macrophages 3. défense antitumorale: cellules NK
V- FONCTIONS 4. Fonctions effectrices de l’immunité à médiation cellulaire: Rôle des LT sécréteurs de lymphokines : rôle dans * régulation de l’activité des LT et LB * régulation de l’hématopoïèse * contrôle de la réponse inflammatoire * HSR ( LTCD 4 helper)
VI- EXPLORATION 1. NFS: - Taux normal des lymphocytes: 1500 - 4000/ mm 3 • 25% de la formule leucocytaire de l’adulte • Inf à 1500/mm 3: Lymphopénie • Sup à 4000/mm 3: Hyperlymphocytose - Nourrissons et enfants: inversion de la formule leucocytaire Lymphocyte: 3000 - 8000/mm 3
VI- EXPLORATION 2. Frottis sanguin: a) Aspect morphologique des lymphocytes - Taille des cellules - Aspect du noyau * forme irrégulière * Chromatine: dense; fine; en mottes * Présence ou non de nucléoles - Aspect du cytoplasme * Abondance * degré de basophilie * régularité ou non des contours * présence d’inclusions azurophiles
VI- EXPLORATION b) Caractère homogène ou hétérogène de la population lymhocytaire c) Réaction à la myélopéroxydase ( - ) MPO -, en cas de lymphocytose avec lymphoblastes
VI- EXPLORATION 3. Myélogramme et BOM: en cas de suspicion de pathologie maligne 4. Immunophénotypage et numération des lymphocytoses Par cytométrie en flux en utilisant les Ac monoclonaux: Anti CD 3 LT / Anti CD 19, CD 20 LB Anti CD 4 LT CD 4/ Anti CD 16 C/ NK Anti CD 8 LT CD 8;
VI- EXPLORATION 5. Exploration de l’hypersensibilité retardé: HSR Intradermoréaction: IDR à la tuberculine 6. Biopsie ganglionnaire Classer avec certitude un lymphome malin non hodgkinien ( LMNH)